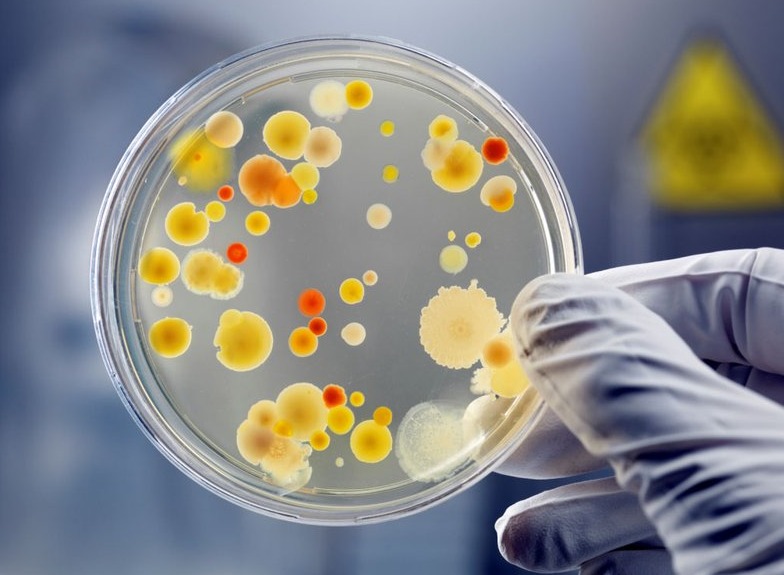
nam-men-trong-thuc-pham-co-loi-hay-co-hai 1.jpg

Tốt nghiệp loại giỏi trường Đại học Y Dược Huế. Từng tham gia nghiên cứu khoa học đề tài về Dược liệu. Nhiều năm kinh nghiệm làm việc trong lĩnh vực Dược phẩm. Hiện đang là giảng viên cho Dược sĩ tại Nhà thuốc Long Châu.
Ngọc Hiếu
07/06/2025
Mặc định
Lớn hơn
Nấm men thực phẩm được ứng dụng trong sản xuất thực phẩm và công nghiệp lên men như sản xuất rượu bia, men sữa chua,... Vậy nấm men trong thực phẩm có lợi hay có hại?
Nấm men là một loại nấm vi sinh có thể được sử dụng trong nhiều ứng dụng khác nhau trong ngành thực phẩm và công nghiệp. Chúng thường được sử dụng để lên men, chuyển hóa các chất liệu nguyên liệu thành các sản phẩm khác có giá trị, như rượu, bia, men làm bánh, men sữa chua, và nhiều loại thực phẩm lên men khác.
Nấm men và nấm mốc là hai dạng nấm thường xuất hiện phổ biến trong môi trường tự nhiên, thường xuất hiện trong môi trường tối và ẩm ướt. Chúng thường có mặt trên trái cây, quả mọng, trong dạ dày của động vật có vú và trên da, cũng như nhiều nơi khác.
Điều đặc biệt là loại nấm này có khả năng phát triển nhanh chóng dưới nhiều điều kiện môi trường khác nhau. Điều này khiến chúng có khả năng tấn công nhiều loại thực phẩm khác nhau và gây hư hỏng, phân hủy thực phẩm một cách đa dạng. Nấm men và nấm mốc thường có khả năng tấn công và phát triển trên hầu hết các loại thực phẩm.
Chúng có thể tấn công các loại cây trồng như ngũ cốc, hạt, đậu và các loại trái cây ngay trên cánh đồng trước khi thu hoạch, và cũng trong quá trình bảo quản sau khi thu hoạch. Ngoài ra, chúng cũng phát triển trên thực phẩm chế biến và các hỗn hợp thực phẩm khác. Khả năng phát hiện nấm trong thực phẩm thường phụ thuộc vào loại thực phẩm và mức độ xâm lấn của nấm.
Thực phẩm bị nhiễm bởi các loại nấm này có thể trải qua quá trình hư hỏng từ nhẹ đến nghiêm trọng hoặc thậm chí bị hỏng hoàn toàn. Chúng thường xuất hiện dưới dạng các đốm thối với kích cỡ và màu sắc khác nhau, tiết ra chất nhờn, hoặc có thể thấy sợi nấm màu trắng hoặc mốc màu. Mùi vị và hương vị của thực phẩm cũng có thể bất thường khi bị nhiễm nấm này. Sự phát triển của nấm có thể không thấy rõ bằng mắt thường, đôi khi chỉ có thể được phát hiện thông qua các xét nghiệm đặc biệt.
Nấm men là một loại sinh vật đơn bào, có đa dạng hình dạng từ hình cầu, hình bầu dục đến hình que và có thể thể hiện những hình dạng khác nhau. Phương thức sinh sản chủ yếu của chúng là thông qua việc nảy chồi. Tuy nhiên, có những loại nấm men có tế bào con không rời khỏi cơ thể mẹ, tiếp tục phát triển thông qua việc nảy chồi trong cùng một cơ thể mẹ. Điều này tạo ra một hình thái khá độc đáo, khiến chúng có hình dạng giống như cây xương rồng khi được quan sát dưới kính hiển vi.
Nấm men có thể có lợi hoặc có hại, vậy ăn nấm có tốt không? Điều này còn tùy thuộc vào cách chúng được sử dụng và loại nấm men cụ thể. Một số loại nấm men có thể gây nhiễm trùng trong trường hợp tiếp xúc quá mức hoặc đối với nhóm người có hệ miễn dịch suy yếu, như người già yếu, người mắc HIV, hoặc những người đang trong giai đoạn điều trị bằng thuốc kháng sinh hoặc hóa trị.

Quản lý chất lượng thực phẩm là rất quan trọng để đảm bảo an toàn khi sử dụng nấm men trong thực phẩm. Sản phẩm thực phẩm chứa nấm men cần tuân thủ các tiêu chuẩn vệ sinh và kiểm tra chất lượng thường xuyên.
Nấm men trong thực phẩm có thể mang lại nhiều lợi ích dinh dưỡng và hương vị, nhưng việc tiếp xúc và sử dụng cần được thực hiện một cách an toàn và có kiểm soát để tránh các vấn đề sức khỏe tiềm ẩn.
Nấm men đóng vai trò quan trọng trong nhiều lĩnh vực:
Sản xuất Ethanol và chất men: Nấm men được sử dụng rộng rãi để sản xuất ethanol cho các đồ uống có cồn như bia, rượu. Ngoài ra, chúng cũng được sử dụng để tạo chất men trong ngành làm bánh. Khả năng chuyển hóa đường thành cồn và các chất men là một trong những ưu điểm quan trọng của chúng.
Thực phẩm bổ sung và nguyên liệu ăn chay: Nấm men cung cấp thêm dinh dưỡng cho người ăn chay và là nguồn cung cấp protein quan trọng. Điều này làm cho chúng trở thành một phần quan trọng của chế độ ăn chay và thực phẩm bổ sung dinh dưỡng.
Nghiên cứu di truyền học: Cấu trúc tế bào đơn giản của nấm men làm cho chúng trở thành một tài nguyên quý giá trong lĩnh vực di truyền học. Các nhà nghiên cứu sử dụng chúng để tìm hiểu và nghiên cứu các quá trình di truyền như chu trình tế bào, sao chép DNA và tái tổ hợp.
Sản xuất thực phẩm và đồ uống: Nấm mốc chủ yếu được sử dụng trong sản xuất thực phẩm và đồ uống. Chẳng hạn, chúng thường được sử dụng để sản xuất nước tương, rượu sake, phô mai, men sữa chua và xúc xích.
Sản xuất thuốc: Nấm mốc cung cấp nguồn nguyên liệu quý cho việc sản xuất thuốc. Các loại thuốc như penicillin, Lovastatin (thuốc hạ cholesterol) và Cyclosporine (thuốc ức chế miễn dịch) được chế tạo từ nấm mốc và đóng vai trò quan trọng trong ngành dược phẩm.
Với đa dạng ứng dụng này, nấm men và nấm mốc đóng vai trò quan trọng không chỉ trong ngành công nghiệp thực phẩm và đồ uống mà còn trong lĩnh vực y học, nghiên cứu di truyền và sản xuất thuốc. Điều này thể hiện tầm quan trọng và sự đa dạng của chúng trong các lĩnh vực khác nhau của ngành khoa học và công nghiệp.
Một số loại nấm mốc, bao gồm cả nấm men, có thể gây nguy hiểm cho sức khỏe con người do chúng tạo ra các hợp chất độc hại được gọi là mycotoxin. Các chất này thường rất ổn định và không bị phá hủy trong quá trình nấu nướng và chế biến thực phẩm.

Tiếp xúc với lượng lớn nấm mốc qua thức ăn hoặc hít phải có thể dẫn đến các vấn đề về sức khỏe, đặc biệt là về dị ứng và hệ hô hấp. Các triệu chứng phản ứng dị ứng có thể bao gồm chảy nước mắt, ngứa mắt, đau khớp mãn tính, đau đầu hoặc đau ở một bên đầu, khó thở, mệt mỏi, phát ban, viêm xoang, tắc mũi và hắt hơi thường xuyên.
Một số loại nấm men cũng có khả năng gây nhiễm trùng ở nhóm người có hệ miễn dịch suy yếu như người già yếu, những người mắc HIV hoặc đang chịu điều trị bằng xạ trị, hóa trị, và kháng sinh. Đặc biệt, nấm men Candida có thể gây nên bệnh nhiễm nấm Candida ở con người.
Vấn đề này đặc biệt quan trọng đối với những người có hệ miễn dịch suy yếu, vì chúng có thể dẫn đến các biến chứng nghiêm trọng. Do đó, việc kiểm soát sự tiếp xúc với nấm mốc trong thức ăn và môi trường sống là rất quan trọng để ngăn ngừa các vấn đề sức khỏe tiềm ẩn.
Tuy nhiên, không phải tất cả nấm mốc đều gây hại cho con người. Có nhiều loại nấm mốc được sử dụng rộng rãi trong sản xuất thực phẩm và y học với mục đích cụ thể như sản xuất các loại thuốc và men sữa chua. Sự hiểu biết về loại nấm mốc cụ thể và cách tiếp xúc với chúng là quan trọng để đảm bảo an toàn cho sức khỏe trong sử dụng và tiêu thụ thực phẩm.
Xem thêm:
Dược sĩ Đại họcNgô Kim Thúy
Tốt nghiệp loại giỏi trường Đại học Y Dược Huế. Từng tham gia nghiên cứu khoa học đề tài về Dược liệu. Nhiều năm kinh nghiệm làm việc trong lĩnh vực Dược phẩm. Hiện đang là giảng viên cho Dược sĩ tại Nhà thuốc Long Châu.